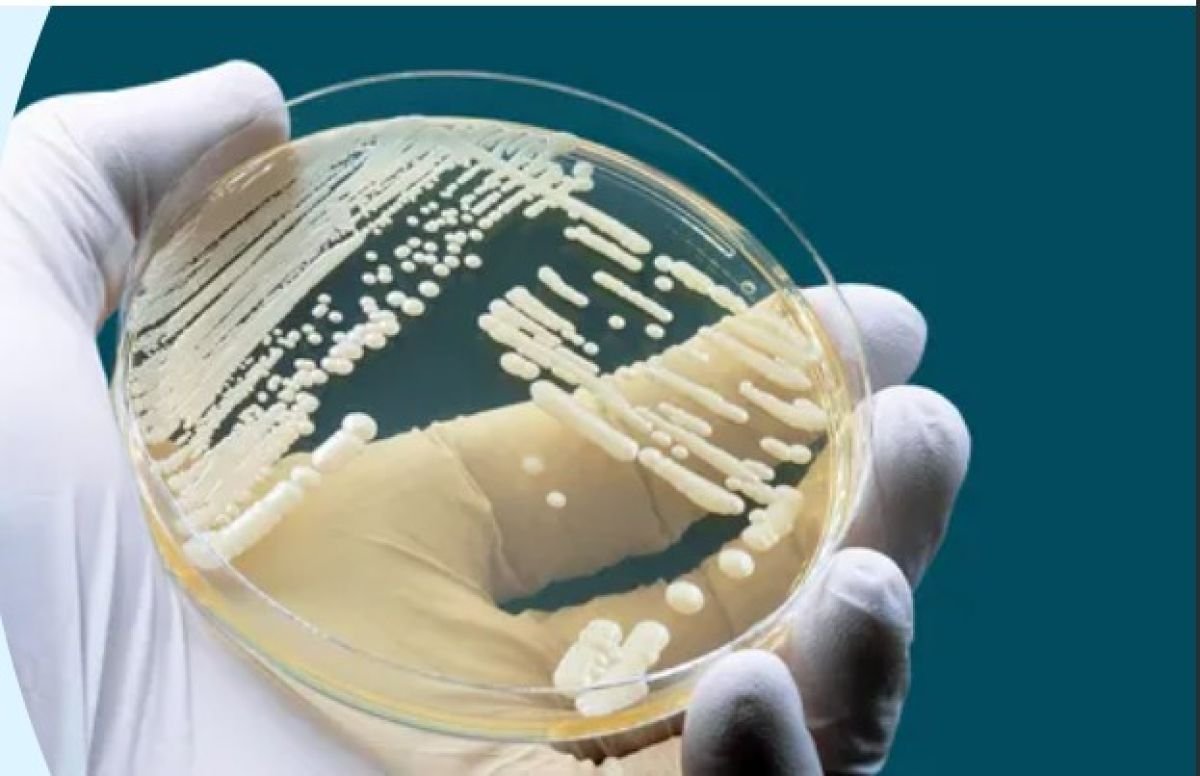

ECDC: Επικίνδυνος μύκητας εξαπλώνεται (και) στα νοσοκομεία της Ελλάδας – Στην 5άδα με τα περισσότερα κρούσματα στην ΕΕ η χώρα μας
Σοβαρή απειλή για τους ασθενείς και τα συστήματα υγειονομικής περίθαλψης αποτελεί ο μύκητας Candidizyma auris ο οποίος σύμφωνα με την πρόσφατη έρευνα του Ευρωπαϊκού Κέντρου Πρόληψης και Ελέγχου Νοσημάτων ECDC συνεχίζει να εξαπλώνεται γρήγορα στα ευρωπαϊκά νοσοκομεία.
Ο αριθμός των κρουσμάτων ανεβαίνει, τα περιστατικά έξαρσης αυξάνονται σε κλίμακα και αρκετές χώρες αναφέρουν συνεχιζόμενη τοπική μετάδοση του μύκητα. Τα ευρήματα υπογραμμίζουν τη σημασία της έγκαιρης ανίχνευσης και του ελέγχου της μετάδοσης για την αποφυγή ευρείας και ταχείας εξάπλωσης.
Το Candidozyma auris (C. auris) είναι ένας μύκητας που συνήθως εξαπλώνεται εντός των εγκαταστάσεων υγειονομικής περίθαλψης, είναι συχνά ανθεκτικός στα αντιμυκητιακά φάρμακα και μπορεί να προκαλέσει βαριές λοιμώξεις σε σοβαρά άρρωστους ασθενείς. Η ικανότητά του να επιμένει σε διαφορετικές επιφάνειες και ιατρικό εξοπλισμό και να εξαπλώνεται μεταξύ ασθενών καθιστά ιδιαίτερα δύσκολο τον έλεγχό του.
Καμπανάκι από τους επιστήμονες
Συνολικά, 4.012 κρούσματα αποικισμού ή μόλυνσης από C. auris αναφέρθηκαν από χώρες της Ευρωπαϊκής Ένωσης (ΕΕ)/Ευρωπαϊκού Οικονομικού Χώρου (ΕΟΧ) μεταξύ 2013 και 2023. Οι πέντε χώρες με τον υψηλότερο αριθμό κρουσμάτων C. auris ήταν η Ισπανία, η Ελλάδα, η Ιταλία, η Ρουμανία και η Γερμανία. Από το 2020, ο αριθμός των κρουσμάτων αυξάνεται ραγδαία μέχρι το 2023, όταν και αναφέρθηκαν 1.346 ετήσια κρούσματα από 18 χώρες ΕΕ/ΕΟΧ.
Παρά την αύξηση αυτή, οι καταγεγραμμένοι αριθμοί κρουσμάτων αντικατοπτρίζουν μόνο την κορυφή του παγόβουνου, καθώς δεν υπάρχει συστηματική επιτήρηση σε πολλές χώρες. Ενώ οι τρεις προηγούμενες έρευνες του ECDC για το C. auris περιορίστηκαν σε χώρες ΕΕ/ΕΟΧ, οι χώρες διεύρυνσης της ΕΕ των Δυτικών Βαλκανίων και η Τουρκία προσκλήθηκαν επίσης να συμμετάσχουν στην έρευνα για το C. auris του 2024. Η Τουρκία, το Κοσσυφοπέδιο και η Βοσνία-Ερζεγοβίνη ανέφεραν συνολικά 121 κρούσματα C. auris.
Πρόσφατα κρούσματα έχουν αναφερθεί στην Κύπρο, τη Γαλλία και τη Γερμανία, ενώ η Ελλάδα, η Ιταλία, η Ρουμανία και η Ισπανία έχουν δηλώσει ότι δεν μπορούν πλέον να διακρίνουν συγκεκριμένες εξάρσεις λόγω της εκτεταμένης περιφερειακής ή εθνικής διασποράς. Η περίοδος μεταξύ ενός καταγεγραμμένου πρώτου κρούσματος στη χώρα και της περιφερειακής ενδημικότητας σύμφωνα με το σύστημα σταδιοποίησης του ECDC ήταν μεταξύ πέντε και επτά ετών για την Ελλάδα, την Ιταλία και την Ισπανία, γεγονός που δείχνει πόσο γρήγορα μπορεί να εξαπλωθεί το C. auris μέσω των νοσοκομειακών δικτύων.
Σε αρκετές από αυτές τις χώρες, έχει σημειωθεί παρατεταμένη τοπική μετάδοση μέσα σε λίγα μόνο χρόνια από το πρώτο καταγεγραμμένο κρούσμα, γεγονός που υπογραμμίζει το κρίσιμο χρονικό περιθώριο για έγκαιρες παρεμβάσεις για την αναχαίτιση της εξάπλωσής του.
Ο Δρ Διαμαντής Πλαχούρας, επικεφαλής του τμήματος Μικροβιακής Αντοχής και Λοιμώξεων που Σχετίζονται με την Υγειονομική Περίθαλψη του ECDC, δήλωσε: «Το C. auris έχει εξαπλωθεί μέσα σε λίγα μόνο χρόνια – από μεμονωμένες περιπτώσεις σε ευρεία εξάπλωση σε ορισμένες χώρες. Αυτό δείχνει πόσο γρήγορα μπορεί να εγκατασταθεί στα νοσοκομεία. Αλλά αυτό δεν είναι αναπόφευκτο. Η έγκαιρη ανίχνευση και ο γρήγορος, συντονισμένος έλεγχος της μόλυνσης μπορούν να αποτρέψουν την περαιτέρω μετάδοση.»
Ενώ ορισμένες χώρες έχουν δείξει θετικά αποτελέσματα στον περιορισμό των κρουσμάτων C. auris, πολλές παρουσιάζουν σημαντικά κενά. Παρά τον αυξανόμενο αριθμό κρουσμάτων, μόνο 17 από τις 36 συμμετέχουσες χώρες διαθέτουν επί του παρόντος εθνικό σύστημα επιτήρησης για το C. auris. Μόνο 15 χώρες έχουν αναπτύξει συγκεκριμένες εθνικές οδηγίες πρόληψης και ελέγχου λοιμώξεων. Η εργαστηριακή ικανότητα είναι συγκριτικά ισχυρότερη, με 29 χώρες να αναφέρουν πρόσβαση σε μυκολογικό εργαστήριο αναφοράς ή σε ειδικό εργαστήριο και 23 να προσφέρουν εξετάσεις αναφοράς για νοσοκομεία.
Ενώ ο αριθμός των λοιμώξεων από C. auris σαφώς αυξάνεται, χωρίς συστηματική επιτήρηση και υποχρεωτική αναφορά, η πραγματική κλίμακα του προβλήματος πιθανότατα δεν αναφέρεται επαρκώς.
Το ECDC αξιολογεί τακτικά την επιδημιολογική κατάσταση, την εργαστηριακή ικανότητα και την ετοιμότητα για το C. auris σε τέσσερις έρευνες από το 2018 και δημοσιεύει ταχείες αξιολογήσεις κινδύνου, συμπεριλαμβανομένων επιλογών για την πρόληψη και τον έλεγχο των λοιμώξεων. Αυτό έχει ως στόχο να υποστηρίξει τα κράτη μέλη στη βελτίωση της ετοιμότητάς τους και των ικανοτήτων έγκαιρης αντίδρασης για την πρόληψη ή τον περιορισμό των κρουσμάτων C. auris εγκαίρως και την πρόληψη περαιτέρω μετάδοσης.
Πηγή: ECDC





